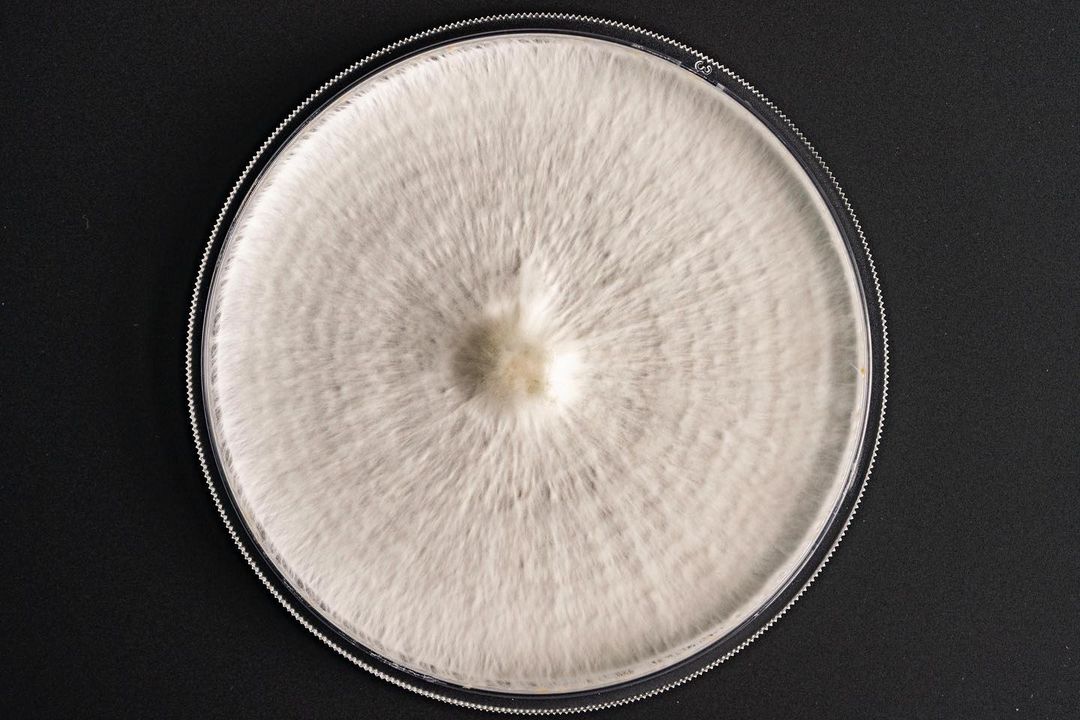

filters
+
WHITE & WHITE | Creative news
19/05/23 US

JON PATERSON
X ELF COSMETICS

CONI TARALLO
X NOUS ÉTUDIONS

ARMIN ZOGBAUM
X STORIES COLLECTIVE

RICHARD PHIBBS
X CARRIE COON for AMAZING

EMIL STEGEMEJER
X LOUIS POULSEN

JUSTIN WILCZYNSKI
Dreamy Malibu day

BRYAN RODNER CARR
X FOR LOVE & LEMONS

KATE HOLLOWELL
X JORDAN FISHER for ALDO

MOLLY CRANNA
X CORRIDOR

SAM NIXON
X ARITZIA

ADAM KATZ SINDING
X COURREGES, Paris

KEITH GREENBAUM
X VEGAMOUR

AARON LIPPMAN
X ISSUE MAGAZINE CL

DANA GALLAGHER
panna cotta

COLIN CLARK
X NICHOLAS MORGENSTERN for THE NEW YORK TIMES

NEIL FAVILA
X PUMA

BLAIR CALDWELL
X BEYONCÉ

THOMAS GIDDINGS
X QUINTA BRUNSON for HARPER'S BAZAAR US

PERRY OGDEN
X BROWN THOMAS

CHARLIE NUCCI
X WALLPAPER*

ROGER NEVE
Underwater Ballet

ELIZABETH WEINBERG
X KALIUCHIS for THE NEW YORK TIMES

RAHIM FORTUNE
X NIA LONG for THE CUT

AUDREY MA
X THE BEVERLY HILLS HOTEL

MIGUEL REVERIEGO
X LUNA KI - CL34N

CHRISTOPHER FENNER
X HUNGER

UWE DUETTMANN
Lea Valencia
MICHAEL CHRISTOPHER BROWN
X NATIONAL GEOGRAPHIC

LAUREN LONCAR
X ALO

REID ROLLS
Martha's Vineyard

SASHA ARUTYUNOVA
X AIRBNB NATIONAL PARKS CAMPAIGN

G.L ASKEW II
X FERRARI SHEPPARD

FELIX WONG
X VALENTINA KOVA

VICTOR PRADO
X SKINCEUTICALS









